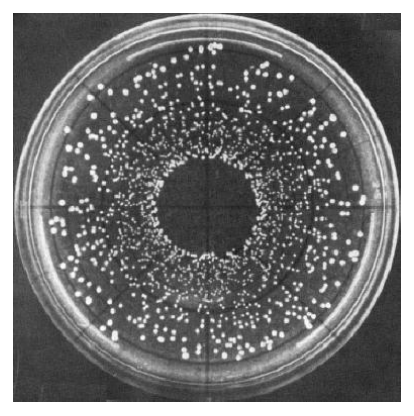
<p><strong>High density cells</strong> to be deposited <u>near the center of the plate</u>, then cells become <u>progressively fewer toward the edge</u></p>

1/63
Looks like no tags are added yet.
Name | Mastery | Learn | Test | Matching | Spaced |
|---|
No study sessions yet.
Culture-dependent technique
Involves rotating plate containing a suitable agar medium
Uses mechanical device that distributes liquid inoculum on the surface
Has dispensing arm that moves from near center of plate to the edge (Archimedes spiral)
Spiral plating

T/F: Spiral plating makes use of a mechanical device with a dispensing arm that moves in an Archimedes spiral manner, that is, from the edge to the near center of the plate
FALSE
Spiral plating makes use of a mechanical device with a dispensing arm that moves in an Archimedes spiral manner, that is, from near the center of the plate toward the edge
What is the expected colony development or distribution in spiral plating?
High density cells to be deposited near the center of the plate, then cells become progressively fewer toward the edge
Rapid and widely used approach to estimating cell numbers in a solution
Relies on the principle that light is scattered in proportion to the number of (unicellular) cells
As no. of cells increases, the amount of light scattered also increases; hence the increase in visible turbidity
Turbidimetric measurement

T/F: Turbidimetric measurement can also be used for multicellular microbes
FALSE
Turbidimetric measurement cannot be used for multicellular microbes because there may be variability in proportionality
Turbidimetric measurement is recommended for _ cultures because bacteria of different sizes will also have different abilities to scatter light
pure
Explain turbidimetric measurement procedures
From an isolated bacterial colony,
you create a pre-culture (broth), then
create a culture (broth) with standardized inoculum (from pre-cultured broth)
Incubate at an appropriate temperature and O2 concentration
Optical density (OD) measurement
Plot standard and growth curves

T/F: Different colors of inoculum in spiral plating may indicate different dilutions
TRUE
T/F: Unless you’ve inoculated log-stage bacteria, turbidity measurement will always measure the total count
TRUE
Stationary, decline = total count because there’s equal division and death rate in stationary (UNLESS CELL LYSES)
T/F: If cells die due to lysis in stationary phase, turbidity indicates total count
FALSE
Turbidity = viable count at this point since spectro won’t be able to measure lysed cells; if cells just die = total count
T/F: It is reasonable to assume turbidity in log-stage bacterial inoculum as viable count
TRUE
Since log-stage bacteria behave identically, then if 1 is viable, most likely they’re all viable; turbidity = viable count
Standard curve vs. Growth Curve
Standard curve (linear)
Optical density (Y) vs. Number of cells (X)
Growth curve (logarithmic)
Optical density (Y) vs. Time (X)


Standard curve or Growth curve?
Optical density (y) vs. Time (x) = logarithmic = Growth curve

Standard curve or Growth curve?
Optical density (y) vs. Number of cells (x) = linear = Standard curve
Principle behind turbidimetric measurement
Rapid, widely used approach for estimating cell numbers in a solution, relying on the principle that
Light is scattered in proportion to the number of cells (unicellular)
As no. of cells increases, so does the amount of light being scattered, resulting in increased visibility of turbidity

_ measures the unscattered light that passes through a sample
Measures 480 nm (blue), 540 nm (green), 600 (orange), 660 (red)
The shorter the wavelengths, the more sensitive, but at high cell densities, it is recommended to use longer wavelengths (less sensitive)
Spectrophotometer

Why is it recommended to use longer wavelengths (for spectrophotometry) for high cell densities?
Bc shorter wavelengths are more sensitive and could cause more light scattering, potentially leading to overestimation of OD
Meanwhile, using longer wavelengths reduce sensitivity to light scattering, providing a more accurate measure of total biomass at high concentrations
_ is the most common wavelength to measure OD bacteria
600 nm (orange)
T/F: Optical density measures scattered light, while spectrophotometer measures unscattered light
TRUE
OD = scattered light = no. of cells
T/F: Optical density is a measure of viable count, not total count
FALSE
Optical density is a measure of total count. It does not distinguish viable from non-viable cells.
_ relates cell number (microscopic or viable count) to turbidity, but its proportionality only holds within limits
Standard curve

T/F: OD600 directly measures only viable cells in a bacterial culture
FALSE
The only 2 instances where turbidity definitely indicates viable count would be _
When analyzing log-stage bacterial inoculum
When dead cells in inoculum have undergone lysis
T/F: 480 nm is more sensitive than 660 nm for detecting bacterial growth
TRUE
T/F: OD600 is the best wavelength for bacterial growth monitoring because bacteria are orange in color
FALSE
OD600 is widely used because it provides moderate sensitivity and avoids extreme light scattering, but it has no relation to bacterial color.
The more cells, the more light scattered, the higher the OD, but the _ (for spectrophotometer)
less unscattered light measured by spectrophotometer
T/F: Optical density and light absorption are the same
FALSE
Optical density measures cell density through light scattered by cells
Light absorption = light absorbed by cells

Limitation of standard curve; how to resolve this issue
It has the assumption that optical density = cell number, but there’s a limit to that
This proportionality only holds within limits, e.g., only for unicellular cells or microbes that grow evenly distributed in suspension in liquid medium
In this case, the proportionality only held within OD 0.5, so what you can do is dilute your sample if it exceeds OD 0.5, measure again, then multiply reading accordingly
e.g., If diluted 1:10 and OD = 0.6, actual OD 0.6 (10) = 6.0
Actual OD = OD measured x DF
Sample Problem on Optical Density and Dilution
A researcher is measuring the optical density (OD) of a bacterial culture at 600 nm. The spectrophotometer reads an OD of 1.2, but the lab protocol states that OD measurements above 0.5 are unreliable due to excessive light scattering.
To obtain an accurate reading, the researcher dilutes the sample 1:5 (1 part culture + 4 parts sterile medium) and measures the OD again. The spectrophotometer now reads 0.3.
Questions:
What is the actual OD of the undiluted bacterial culture?
If the OD is proportional to cell concentration, how much more concentrated is the original sample compared to the diluted one?
Actual OD = OD measured (after exceeding OD limit) x DF
= 0.3 × 5 = 1.5
Since OD is proportional to cell concentration, the original culture is 5 times more concentrated than the diluted one

Explain figure shown
Growth curve = optical density (y) vs. time (x)
This allows us to compare the growth rate of microorganisms
Organism A grows faster than Organism B because it reaches a much higher OD at a shorter period of time (or less doubling time = faster doubling time)
This implies that the slower-growing organism (B) would have a higher doubling time than faster-growing organism (A)
T/F: In a growth curve, a slower-growing organism would usually have higher doubling time than faster-growing organism
TRUE

T/F: Spectrophotometer measures the scattered light that passes through a sample
FALSE
Spectrophotometer measures the unscattered light that passes through a sample
Advantages and Disadvantages of Turbidimetric Measurement
Advantages qrn
Quick and easy to perform
Readily repeatable
No adverse effects on cells (u can use it again as long as u keep it sterile)
Disadvantages vluo
Very sensitive (can lead to changes in reading if u disrupt/agitate sample)
Limited to unicellular microbes, microbes that grow evenly distributed in suspension in liquid medium
Prone to underestimation
especially clumps/biofilms, which may contain hundreds of cells, but only scatter light once
<107 cells/mL = not detected
Prone to overestimation
Deeply colored cultures
Suspended matter
_ refers to the statistical determination of viable cells
Suitable for samples with too few organisms or cells that do not grow on solid medium, e.g., agar
Commonly used for food and water sanitation studies (coliform detection)
Most Probable Number (MPN)
3 indicators of a positive result in MPN tubes
get
Gas production (bubbles)
Effervescence
Turbidity
Explain MPN procedure
Homogenize sample
Inoculate 3 sets of tubes with different vols of inoculum, e.g., 10 mL, 1 mL, 0.1 mL (each responding to diff dilution)
Incubate
Score tubes as (+) or (-)
(+) = both gas production, turbidity
If after 24 h, there no growth (or just turbidity but not gas) = negative
e.g., 10 mL = 5; 1 mL = 2, 0.1 mL = 0
Could be 3-tube method, 5-tube method
MPN index = 50 organisms / 100 mL


Comprehension check for MPN index
Solve ff. table
Sample A = 160 MPN/g
40 - 420 MPN/g
Sample B = 20 MPN/g
4.5 - 42 MPN/g
Explain other way through which MPN may be performed
Create serial dilution of sample
1 mL of each dilution is inoculated into triplicates of growth medium
Observe growth; 1st set of dilution tubes that fails to grow will be used to bracket a set of 3 dilutions (include 2 preceding dilution tubes)
Use MPN table, multiply MPN index to DF of middle tube set
MPN index = 0.43 × 10^4 = 4.3×103 microbes/mL of sample

Advantages and Disadvantages of MPN
Advantages rs
Relatively simple and easy
Specific groups of organisms may be determined using appropriate selective and differential media
Disadvantages lvop
Large volumes of glassware required
Lack of opportunity to observe colony morphology of organisms
Lack of precision (generally higher than SPC)
Culture-dependent technique
Involves use of membrane filter with pore size that retains microbial cells but allows diluent or water to pass
Bacteria = _ um
Fungi = _ um
Membrane filtration
Bacteria = 0.22 um
Fungi = 0.45 um
Explain membrane filtration procedure
Filter sample through membrane filter with pore size appropriate to microbe-of-interest
Place membrane to an agar plate or a medium saturated-absorbent pad
Incubate
Enumerate colonies

Culture-dependent technique
Involves counting microcolonies in an agar-layered microscope slide
Microscope colony count
Explain microscope colony count procedure
Inoculate agar-layered microscope slide with sample
Incubate
Dry
Stain
Count microcolonies under microscope

Culture-dependent technique
Viable count
Faster than conventional plate count
Food homogenate is diluted in tubes of molten agar
Agar Droplet Count
Explain agar droplet count procedure
+ 1 mL of homogenate into (9 mL) of agar tube 1, mix
then 0.1 mL of agar tube 1 mix to 9.9 mL of agar tube 2, mix
then 0.1 mL of agar tube 2 mix to 9.9 mL of agar tube 3, mix
Use sterile capillary pipette (ideally delivering 0.033 mL/drop) to transfer five 0.1 mL droplets (per dilution) to bottom of petridish
Incubate
Enumerate colonies with 10x viewer

Miles and Misra vs. Agar Droplet Count
Miles & Misra
Pre-solidified media
Only 1 replicate for each dilution
Diluent = liquid (e.g., Peptone water)
Agar Droplet Count
Empty plate (no media)
Have several replicates for each dilution
Diluent = agar
Culture-dependent technique
Estimates number of viable organisms
Properly prepared supernatants of food are added to standard solutions of dye
Time for dye reduction is inversely proportional to number of organisms
Longer amount of time it takes for dye to reduce = smaller no. of organisms
Faster/shorter amount of time for dye reduction = larger no. of organisms
Methylene blue = blue → white
Resazurin = blue → pink
Dye reduction

Advantages and disadvantages of dye reduction
Advantages siro
Simple
Inexpensive
Rapid
Only viable cells actively reduce dyes
Disadvantages
Not all organisms reduce dyes equally
Not applicable to food specimens containing reductive enzymes
Culture-dependent technique
Excellent method for enumerating fastidious anaerobes and microaerophiles
Predetermined amounts of molten inoculated agar are added to tube
Agar is made to solidify as a thin layer on the inside of the tube
H2 + CO2 (80:20) gases to make it anaerobic
Roll tube

Culture-dependent technique
Consists of 2 plastic films
Attached together on one side
Consists of culture medium ingredients
Consists of cold-water-soluble jelling agent
Correlated with conventional plate method
Rehydratable dry film
Culture-dependent technique
Measures enzyme activity through fluorescence
Enzymes + substrate → fluorescent compounds
Fluorescence is detected under long-wave UV light
SimPlate (for HPC)
8 different types of microbiological examination of surfaces
ssr adsus
Swab
Swab-rinse
Replicate organism direct agar contact (RODAC)
Agar syringe / “Agar sausage”
Direct surface agar plating
Sticky film
Ultrasonic
Spray gun
_ is the oldest and most widely used method for the microbiological examination of surface
Swab method
_ involves use of cotton or calcium alginate swab
Templates may be prepared with openings corresponding to size of area to be swabbed
Exposed swab is suspended in suitable diluent
Can be stored at refrigerator temperatures until plated
Swab-rinse method
_ involves raised agar surface in special Petri plates
When plates are inverted, hardened agar makes direct contact with surface
Replicate organism direct agar contact (RODAC)
_ creates a hollow cylinder out of a 100-mL syringe (remove needle end)
Layer of agar is pushed beyond end of barrel by means of plunger and pressed against surface to be examined
Exposed layer is cut off and placed in petri-dish, followed by incubation and colony enumeration
Agar sausage = employ plastic tubing rather than modified syringe
Agar syringe method
_ involves pouring molten agar directly onto surface or utensils to be assessed
Upon hardening, agar mold is placed in Petri dish and incubated
Enumeration of particles containing viable microorganisms
Direct surface agar plating
_ involves pressing sticky film or tape against surface to be examine
Press exposed side on agar plate
Less effective than swabs in recovering bacteria from wooden surfaces
Sticky film
_ is used for small and removable surfaces
Immersed in a diluent
Energy generated effects the release of microorganisms into diluent
Ultrasonic devices
_ is based on impingement of a spray of washing solution against a circumscribed area of surface
Subsequent plating of washing solution
Much more effective than swab method in removing bacteria from meat surfaces
Spray gun
Major characteristics of a metabolically injured microorganism
iind
Increased lag phase (wait it out) and inability to form colonies on selective media
Increased sensitivity to various selective agents
Nonfunctional ribosomes
Damaged DNA and cell membrane
Enumerate environmental stressors causing metabolic injury
ad sfd iass heo
Antibiotics
Dyes
Sublethal heat
Freezing and freezedrying
Drying
Irradiation
Aerosolization
Sodium azide
Salts
Heavy metals
Essential oils
Other chemicals
How do you conduct detection and recovery for metabolically injured microorganisms?
Plate aliquots separately into a general purpose / nonselective medium and a selective medium
Difference between number of colonies on 2 media is a measure of the number of injured cells in the original culture or population
Colonies that grew on general purpose and did not on selective are most likely the MI ones, so inoculate these onto a recovery medium, e.g., nutrient broth
Explain advantages and disadvantages of culture-dependent techniques
Advantages arqh
Assesses living + culturable microbes
Allows us to recognize viable cells
Easy to quantitate cells in sample
High sensitivity with appropriate media
Disadvantages rhtp
Risk of contamination
High skill level is necessary for optimal results
Time- and resource-intensive
Relies on phenotypic biochemical characterization